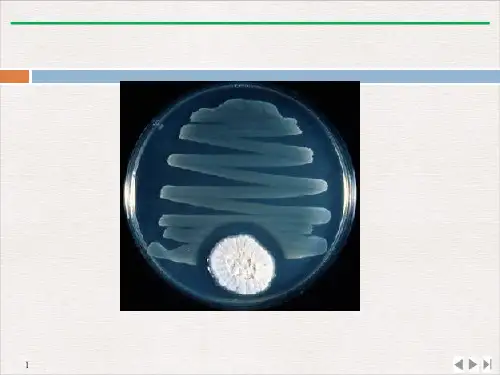

微生物抗药性及生态效应精品PPT课件
- 格式:pptx
- 大小:10.98 MB
- 文档页数:8


第九讲微生物耐药性及生态效应一、微生物耐药机制1 超级细菌:是对所有抗生素有抗药性的细菌的统称。
不仅具有NDM-1的基因,还具有其耐药基因,多个耐药基因组合,就构成了多重耐药。
目前可以治疗超级细菌的抗生素只有替加环素和多粘菌素。
质粒的可移动性和可塑性可能意味着在细菌中的广泛传播和不断变异.2细菌耐药机制一种抗生素可以有不同的抗性机制不同种类的抗生素可以有相同的抗性机制(1)孔蛋白改变,细胞壁/ 膜的通透性改变万古霉素(vancomycin ):由一种链霉菌产生的、结构复杂的糖肽类抗生素,专一地抑制肽聚糖的生物合成。
这种药物通过干扰细菌细胞壁结构中的一种关键组分来干扰细胞壁的合成,抑制细胞壁中磷脂和多肽的生成,只是针对革兰氏阳性菌,对厌氧菌和革兰氏阴性细菌无效。
(2)主动外排泵主动外排泵因为外排泵的主动输出抗生素,因而细菌内达不到治疗浓度。
一些泵具有相对较强的特异性,如四环素运输泵,而其他输出泵具有广泛的底物选择性和耐药性。
细菌体内具有大量的输出泵,用于运输代谢物和外来有毒物质。
(3)酶解抗生素比如β-内酰胺酶能水解β-内酰胺类抗生素,使得β-内酰胺环断裂,从而是抗生素失去活性。
(4)抗生素靶点修饰通过对抗生素靶点的修饰作用,抗生素的靶点变为一种不敏感的形式,从而产生了对抗生素的耐药性。
3 β-内酰胺类抗生素a.定义:是指化学结构中含有β-内酰胺环的一类抗生素b.分类:青霉素类、头孢菌素类、非典型β-内酰胺类c.抗菌机制:抑制细菌细胞壁的合成。
d.新型β-内酰胺类抗生素的发现:方法一:建立文库、筛选阳性克隆、测序方法二:接合或转化实验、质粒提取、测序二、基因水平转移1 机制:2基因水平转移(Horizontal Gene Transfer):是指在差异生物个体之间,或单个细胞内部细胞器之间所进行的遗传物质的交流。
基因水平转移是微生物进化的重要动力,质粒是基因水平转移的重要载体3Pan-genome 泛基因组:在分子生物学中泛基因组是描述一个物种的所有基因序列的总和(通常实用于细菌和古菌,在它们亲缘关系很近的基因含量中有大量的变异),它是超集了一个物种所有家族里的所有基因。